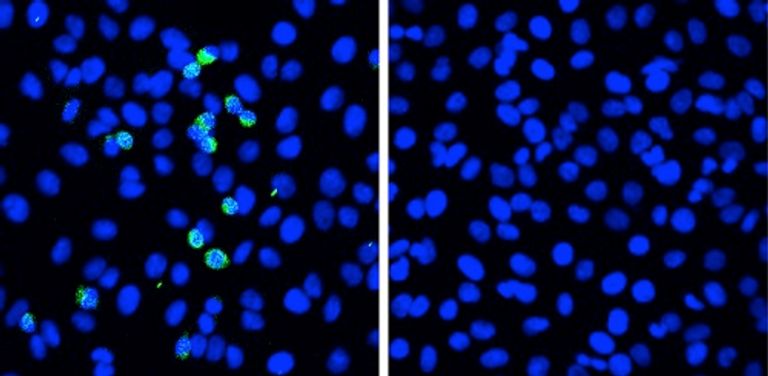
عندما تتعرض الخلايا الرئوية التي لا تعبر عن بروتين RIG-I (يسار) لفيروس كورونا، يتم اكتشاف بروتينات سبايك الفيروسية (الخضراء) في أقرب وقت بعد 5 أيام بعد التعرض، و في الخلايا الطبيعية (على اليمين) ، يتم قمع تكاثر الفيروس غياب بروتين ( RIG-I ) يساعد في تمكين كورونا

اكتشاف سلاح جديد للجسم ضد كورونا.. بروتين الشفاء
اكتشف علماء من جامعة هوكايدو اليابانية استجابة دفاعية جديدة لفيروس كورونا المستجد، تتضمن مستقبل التعرف على النمط الفيروسي ( RIG-I ).
ويمكن أن يؤدي تنظيم التعبير عن هذا البروتين إلى تقوية الاستجابة المناعية لدى الحالات المزمنة من المرض.
وفي الأشهر الثمانية عشر التي انقضت منذ الإبلاغ عن "كوفيد -19" وانتشار الوباء، كان هناك قدر كبير من الأبحاث لفهمه وتطوير حلول لعلاجه.
ولا يؤثر (كوفيد -19) على جميع الأفراد المصابين بالتساوي، فالعديد من الأفراد يصابون بدون أعراض، ومن بين أولئك الذين تظهر عليهم الأعراض، فإن الغالبية العظمى لديهم أعراض خفيفة، وعدد قليل فقط لديهم حالات حادة، وأسباب ذلك ليست مفهومة تمامًا، وهي مجال مهم للبحث المستمر.
وأظهر فريق من العلماء من جامعة هوكايدو، بقيادة البروفيسور أكينوري تاكاوكا من معهد الطب الوراثي، أن المستقبل ( RIG-I ) وهو جزيء بيولوجي يكتشف فيروسات الحمض النووي الريبي، يحد من تكاثر فيروس كورونا المستجد في خلايا الرئة البشرية، ونُشرت النتائج التي توصلوا إليها، والتي يمكن أن تساعد في التنبؤ بنتائج مرضى (كوفيد -19)، في العدد الأخير من مجلة "نيتشر أميونولوجي"
وحتى الآن ، تأثر أكثر من 162 مليون شخص بالفيروس، وحوالي 40٪ -45٪ من هؤلاء الأفراد بدون أعراض؛ أما بالنسبة للبقية، فقد عانى حوالي 35٪ - 40٪ من شكل خفيف من المرض، بينما تأثرت نسبة 19٪ المتبقية بأعراض كانت شديدة بما يكفي لتبرير دخول المستشفى أو كانت قاتلة، والتي ترتبط عادةً بالأمراض المصاحبة وعوامل الخطر مثل مرض الانسداد الرئوي المزمن (COPD)، وتشير هذه المجموعة من الأعراض إلى وجود اختلافات شاسعة بين الاستجابات الفردية للفيروس.
ويتم الكشف عن مسببات الأمراض الميكروبية في أجسامنا بواسطة بروتينات تسمى مستقبلات التعرف على الأنماط (PRRs)، والتي تؤدي أيضًا إلى استجابات مناعية لمسببات الأمراض هذه.
وتم الكشف عن العدوى الفيروسية بواسطة مجموعة فرعية من مستقبلات PRRs ، وركز العلماء انتباههم على البروتين RIG-I ، الذي ينتمي إلى هذه المجموعة الفرعية، ومن المعروف أن هذا البروتين مهم للكشف عن فيروسات الحمض النووي الريبي (RNA) والاستجابة لها مثل فيروس الأنفلونزا.
وفي التجارب التي أجريت في خطوط زراعة الخلايا، وجد العلماء أن هناك القليل من الاستجابة المناعية الفطرية للفيروس في الخلايا الرئوية، مما يشير إلى إحباط مسار الإشارات المؤدي إلى الاستجابة المناعية، ومع ذلك، تم قمع تكاثر الفيروس. وحقق العلماء في دور هذا البروتين ووجدوا أن نقصه تسبب في زيادة تكاثر الفيروس، وأكدت تجارب أخرى أن قمع تكاثر الفيروس كان يعتمد على بروتين RIG-I.
aXA6IDIxNi43My4yMTYuNTYg جزيرة ام اند امز